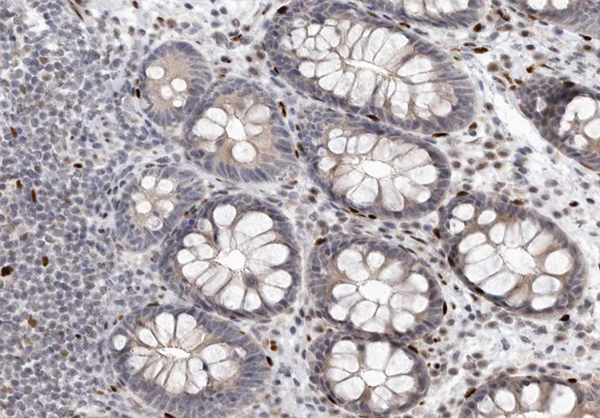
product-image-AAA321445_IHC13.jpg

Rabbit Abl Polyclonal Antibody | anti-ABL1 antibody
Phospho-Abl (Tyr393/412) Antibody
Phosphate buffered saline, pH 7.4, 150mM NaCl, 0.02% sodium azide and 50% glycerol.
IF (Immunofluorescence)
(AAA321445 staining COS7 by IF/ICC. The sample were fixed with PFA and permeabilized in 0.1% Triton X-100, then blocked in 10% serum for 45 minutes at 25 degree C. The primary antibody was diluted at 1/200 and incubated with the sample for 1 hour at 37 degree C. An Alexa Fluor 594 conjugated goat anti-rabbit IgG (H+L) Ab, diluted at 1/600, was used as the secondary antibody.)
WB (Western Blot)
(Western blot analysis of Abl phosphorylation expression in RAW264.7 whole cell lysates, The lane on the left is treated with the antigen-specific peptide.)
IHC (Immunohiostchemistry)
(AAA321445 at 1/200 staining human colon carcinoma tissue sections by IHC-P. The tissue was formaldehyde fixed and a heat mediated antigen retrieval step in citrate buffer was performed. The tissue was then blocked and incubated with the antibody for 1.5 hours at 22 degree C. An HRP conjugated goat anti-rabbit antibody was used as the secondary.)
IF (Immunofluorescence)
(AAA321445 staining K562 cells by ICC/IF. Cells were fixed with PFA and permeabilized in 0.1% saponin prior to blocking in 10% serum for 45 minutes at 37 degree C. The primary antibody was diluted 1/400 and incubated with the sample for 1 hour at 37 degree C. A Alexa Fluor 594 conjugated goat polyclonal to rabbit IgG (H+L), diluted 1/600 was used as secondary antibody.)
Function: Non-receptor tyrosine-protein kinase that plays a role in many key processes linked to cell growth and survival such as cytoskeleton remodeling in response to extracellular stimuli, cell motility and adhesion, receptor endocytosis, autophagy, DNA damage response and apoptosis. Coordinates actin remodeling through tyrosine phosphorylation of proteins controlling cytoskeleton dynamics like WASF3 (involved in branch formation); ANXA1 (involved in membrane anchoring); DBN1, DBNL, CTTN, RAPH1 and ENAH (involved in signaling); or MAPT and PXN (microtubule-binding proteins). Phosphorylation of WASF3 is critical for the stimulation of lamellipodia formation and cell migration. Involved in the regulation of cell adhesion and motility through phosphorylation of key regulators of these processes such as BCAR1, CRK, CRKL, DOK1, EFS or NEDD9. Phosphorylates multiple receptor tyrosine kinases and more particularly promotes endocytosis of EGFR, facilitates the formation of neuromuscular synapses through MUSK, inhibits PDGFRB-mediated chemotaxis and modulates the endocytosis of activated B-cell receptor complexes. Other substrates which are involved in endocytosis regulation are the caveolin (CAV1) and RIN1. Moreover, ABL1 regulates the CBL family of ubiquitin ligases that drive receptor down-regulation and actin remodeling. Phosphorylation of CBL leads to increased EGFR stability. Involved in late-stage autophagy by regulating positively the trafficking and function of lysosomal components. ABL1 targets to mitochondria in response to oxidative stress and thereby mediates mitochondrial dysfunction and cell death. In response to oxidative stress, phosphorylates serine/threonine kinase PRKD2 at 'Tyr-717' (PubMed:28428613). ABL1 is also translocated in the nucleus where it has DNA-binding activity and is involved in DNA-damage response and apoptosis. Many substrates are known mediators of DNA repair: DDB1, DDB2, ERCC3, ERCC6, RAD9A, RAD51, RAD52 or WRN. Activates the proapoptotic pathway when the DNA damage is too severe to be repaired. Phosphorylates TP73, a primary regulator for this type of damage-induced apoptosis. Phosphorylates the caspase CASP9 on 'Tyr-153' and regulates its processing in the apoptotic response to DNA damage. Phosphorylates PSMA7 that leads to an inhibition of proteasomal activity and cell cycle transition blocks. ABL1 acts also as a regulator of multiple pathological signaling cascades during infection. Several known tyrosine-phosphorylated microbial proteins have been identified as ABL1 substrates. This is the case of A36R of Vaccinia virus, Tir (translocated intimin receptor) of pathogenic E.coli and possibly Citrobacter, CagA (cytotoxin-associated gene A) of H.pylori, or AnkA (ankyrin repeat-containing protein A) of A.phagocytophilum. Pathogens can highjack ABL1 kinase signaling to reorganize the host actin cytoskeleton for multiple purposes, like facilitating intracellular movement and host cell exit. Finally, functions as its own regulator through autocatalytic activity as well as through phosphorylation of its inhibitor, ABI1. Regulates T-cell differentiation in a TBX21-dependent manner. Phosphorylates TBX21 on tyrosine residues leading to an enhancement of its transcriptional activator activity (By similarity).
Subunit Structure: Interacts with SORBS1 following insulin stimulation. Found in a trimolecular complex containing CDK5 and CABLES1. Interacts with CABLES1 and PSTPIP1. Interacts with ZDHHC16, ITGB1 and HCK (By similarity). Interacts with STX17; probably phosphorylates STX17. Interacts with INPPL1/SHIP2. Interacts with the 14-3-3 proteins, YWHAB, YWHAE, YWHAG, YWHAH, SFN AND YWHAZ; the interaction with 14-3-3 proteins requires phosphorylation on Thr-735 and, sequesters ABL1 into the cytoplasm. Interacts with ABI1, ABI2, BCR, CRK, FGR, FYN, HCK, LYN, PSMA7 RAD9A, RAD51, RAD52, TP73 and WASF3. A complex made of ABL1, CTTN and MYLK regulates cortical actin-based cytoskeletal rearrangement critical to sphingosine 1-phosphate (S1P)-mediated endothelial cell (EC) barrier enhancement. Interacts (via SH3 domain) with CASP9; the interaction is direct and increases in the response of cells to genotoxic stress and ABL1/c-Abl activation. Found in a complex with ABL1, ABL2, CRK and UNC119; leading to the inhibition of CRK phosphorylation by ABL kinases. Interacts with TBX21 (By similarity).
Post-translational Modifications: Acetylated at Lys-711 by EP300 which promotes the cytoplasmic translocation. Phosphorylation at Tyr-70 by members of the SRC family of kinases disrupts SH3 domain-based autoinhibitory interactions and intermolecular associations, such as that with ABI1, and also enhances kinase activity. Phosphorylation at Tyr-226 and Tyr-393 correlate with increased activity. DNA damage-induced activation of ABL1 requires the function of ATM and Ser-446 phosphorylation (By similarity). Phosphorylation at Ser-569 has been attributed to a CDC2-associated kinase and is coupled to cell division (By similarity). Phosphorylation at Ser-618 and Ser-619 by PAK2 increases binding to CRK and reduces binding to ABI1. Phosphorylation on Thr-735 is required for binding 14-3-3 proteins for cytoplasmic translocation. Phosphorylated by PRKDC (By similarity). Polyubiquitinated. Polyubiquitination of ABL1 leads to degradation.
Similarity: Belongs to the protein kinase superfamily. Tyr protein kinase family. ABL subfamily.
NCBI and Uniprot Product Information
Predicted: 123 kDa
Customer Reviews
Loading reviews...
Share Your Experience
Similar Products
Product Notes
The ABL1 abl1 (Catalog #AAA321445) is an Antibody produced from Rabbit and is intended for research purposes only. The product is available for immediate purchase. The Phospho-Abl (Tyr393/412) Antibody reacts with Human, Mouse, Monkey and may cross-react with other species as described in the data sheet. AAA Biotech's Abl can be used in a range of immunoassay formats including, but not limited to, ELISA, ICC (Immunocytochemistry), IF (Immunofluorescence), IHC (Immunohistochemistry), WB (Western Blot). Researchers should empirically determine the suitability of the ABL1 abl1 for an application not listed in the data sheet. Researchers commonly develop new applications and it is an integral, important part of the investigative research process. It is sometimes possible for the material contained within the vial of "Abl, Polyclonal Antibody" to become dispersed throughout the inside of the vial, particularly around the seal of said vial, during shipment and storage. We always suggest centrifuging these vials to consolidate all of the liquid away from the lid and to the bottom of the vial prior to opening. Please be advised that certain products may require dry ice for shipping and that, if this is the case, an additional dry ice fee may also be required.Precautions
All products in the AAA Biotech catalog are strictly for research-use only, and are absolutely not suitable for use in any sort of medical, therapeutic, prophylactic, in-vivo, or diagnostic capacity. By purchasing a product from AAA Biotech, you are explicitly certifying that said products will be properly tested and used in line with industry standard. AAA Biotech and its authorized distribution partners reserve the right to refuse to fulfill any order if we have any indication that a purchaser may be intending to use a product outside of our accepted criteria.Disclaimer
Though we do strive to guarantee the information represented in this datasheet, AAA Biotech cannot be held responsible for any oversights or imprecisions. AAA Biotech reserves the right to adjust any aspect of this datasheet at any time and without notice. It is the responsibility of the customer to inform AAA Biotech of any product performance issues observed or experienced within 30 days of receipt of said product. To see additional details on this or any of our other policies, please see our Terms & Conditions page.Item has been added to Shopping Cart
If you are ready to order, navigate to Shopping Cart and get ready to checkout.